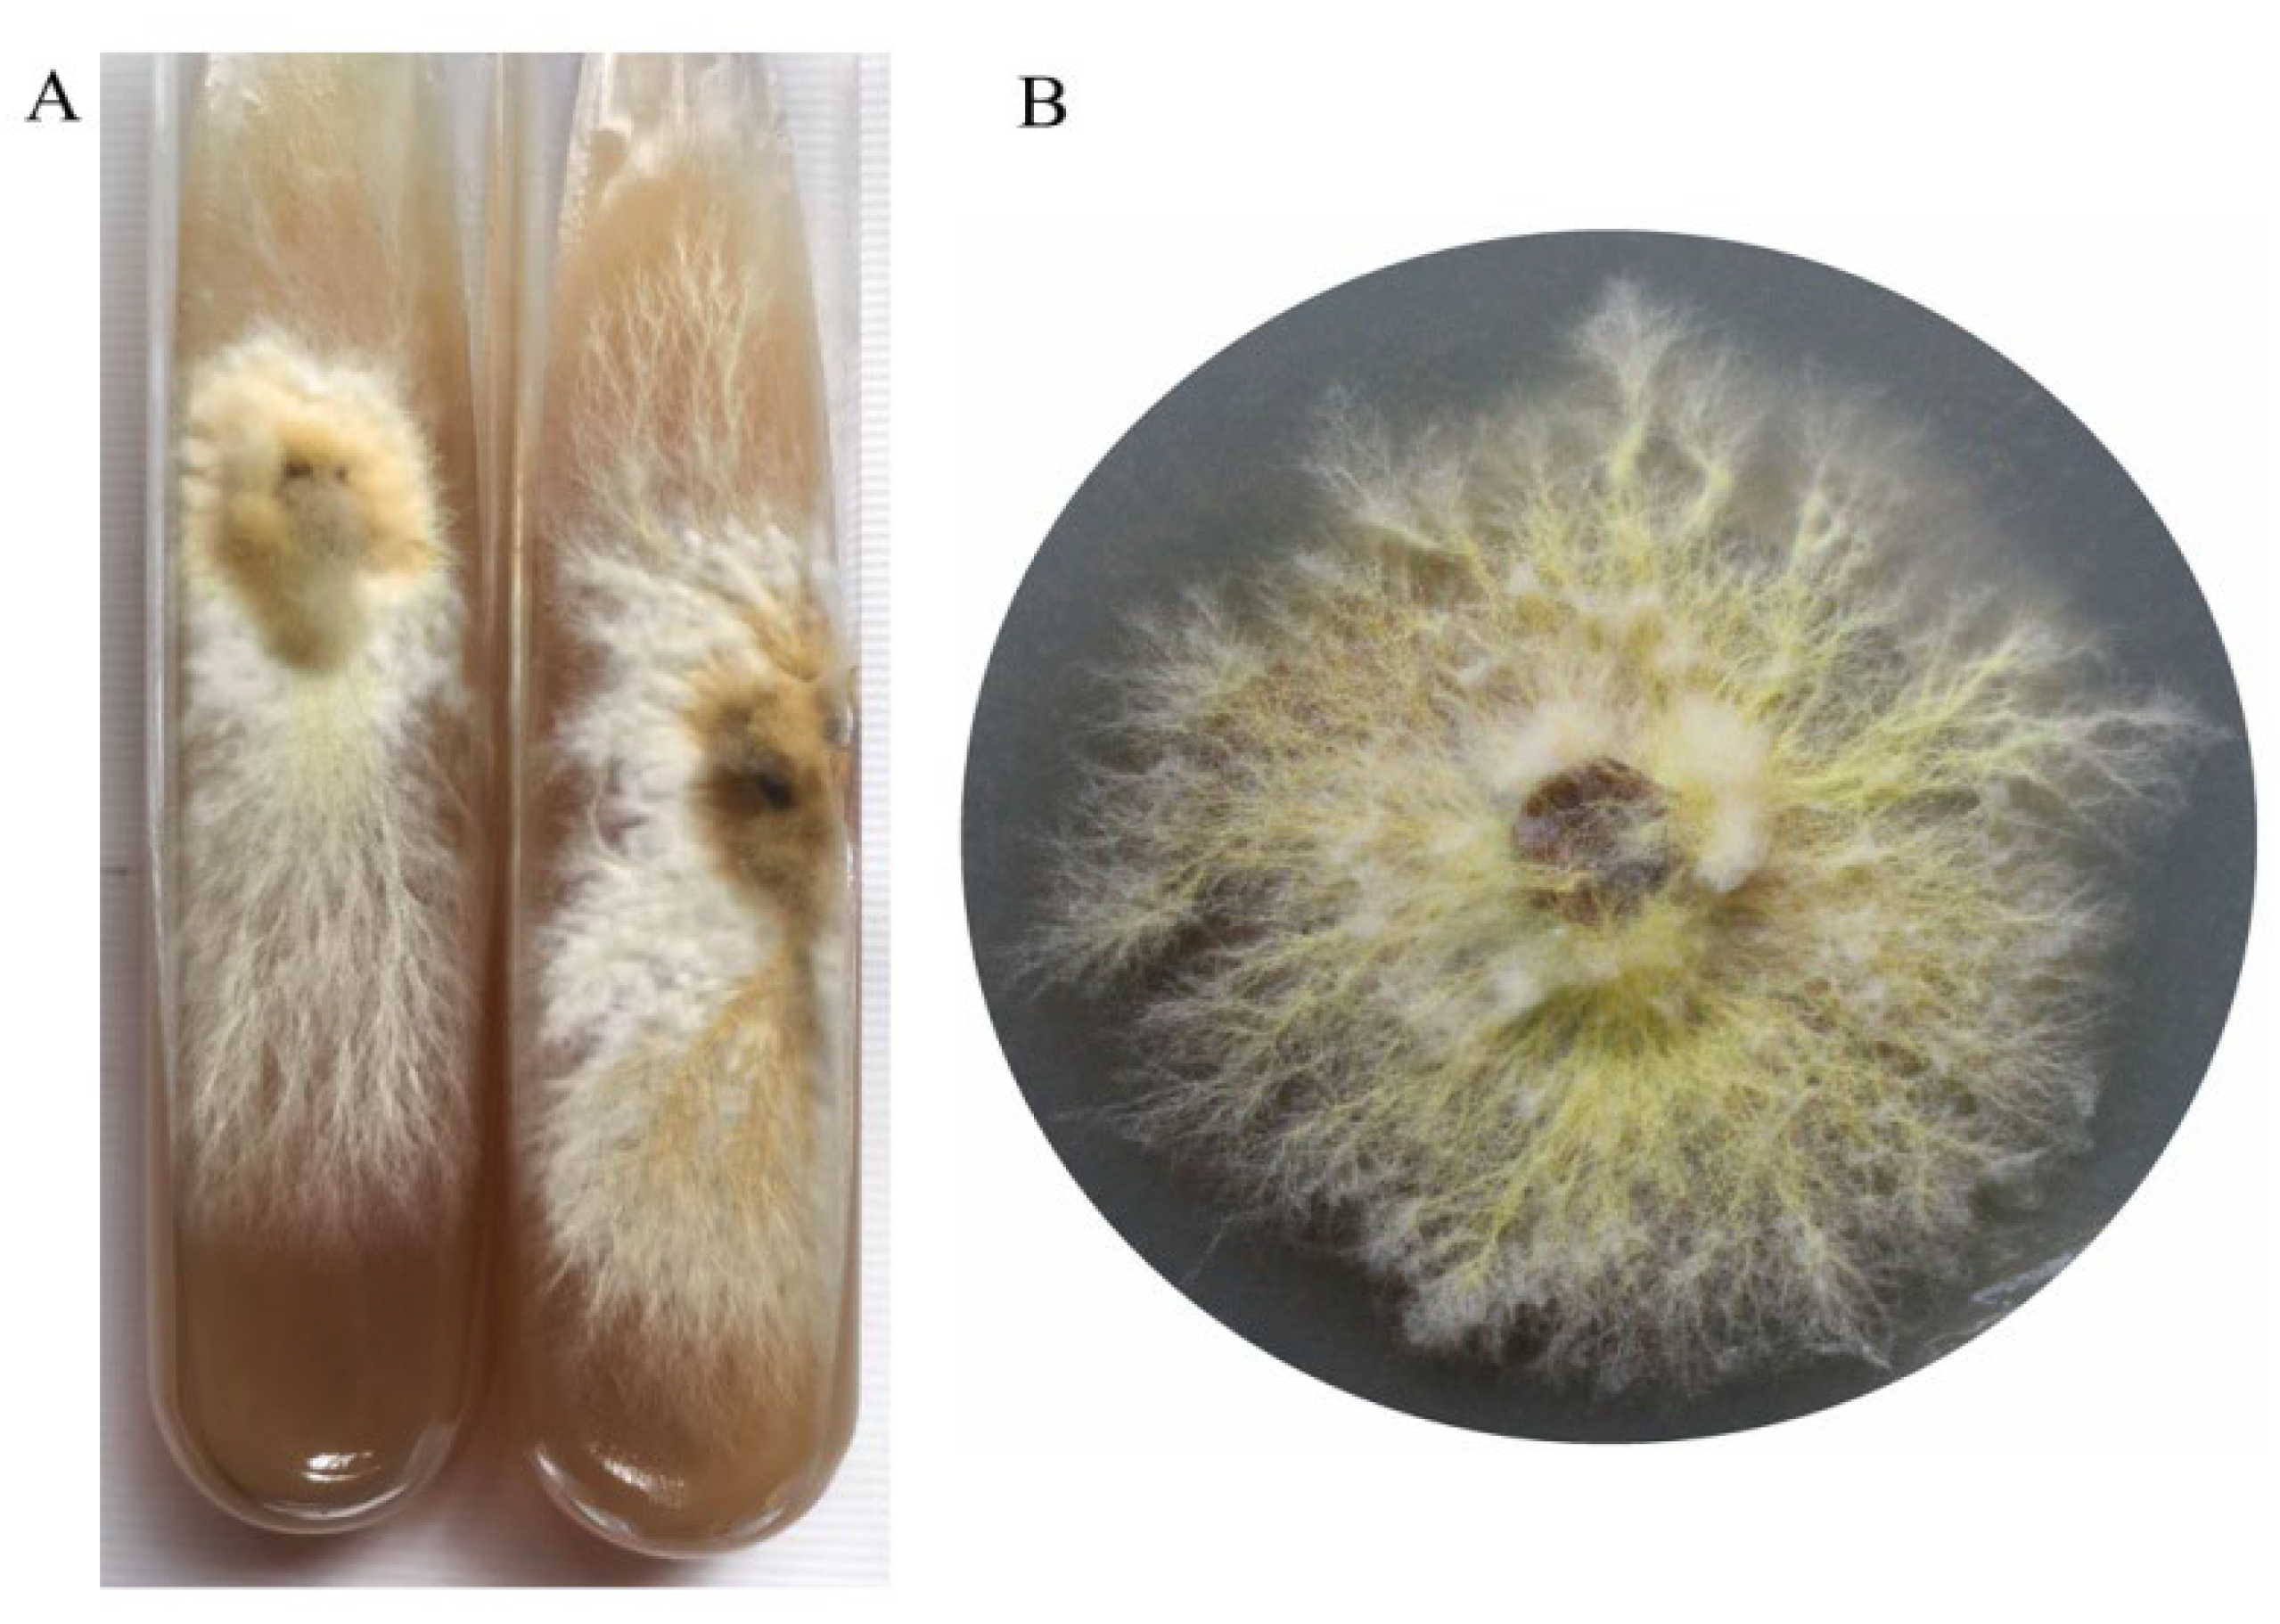
Preprints 142075 g002

1. Introduction
Boletes is one of the important groups of macrofungi [
1,
2,
3]. China has abundant resources of boletes, and nearly 500 species have been reported [
4,
5,
6]. The majority of boletes species are mycorrhizal fungi, which can establish a mutually beneficial symbiotic relationship with various higher plants, including Pinaceae, Salicaceae, Betulaceae, Casuarinaceae, Fabaceae and Dipterocarpaceae [
7,
8,
9,
10,
11]. However, the artificial cultivation of boletus remains challenges. At present, there are only a few types of boletes that can be artificially cultivated. In 1969, Pilat took
Buchwaldoboletus lignicola as a model species and formally established the genus
Buchwaldoboletus and classified it into the Boletaceae family [
12]. This genus distributed all over the world, and 12 species have been described so far [
13]. Predominantly,
Buchwaldoboletus species are wood-rot fungi, typically found growing on decomposed wooden stakes, decomposed rubber sawdust, and in the bamboo forests [
14,
15,
16].
Buchwaldoboletus xylophilus (Petch) Both & B. Ortiz, is an infrequently encountered boletes species native to tropical regions with the wild fruiting bodies which are exceptionally rare and are known to occur in select locations within China, including Xishuangbanna, Hainan and Hong Kong [
13,
17]. They are also distributed in Sri Lanka, Malaysia, India, and the Philippines [
13,
18,
19,
20]. In 2020, we collected a rare species of
boletes in the rubber woodland of Xishuangbanna Dai Autonomous Prefecture, Yunnan Province. Through morphological and molecular biological identification, it was determined that the species is a member of the family Boletaceae and the genus
Buchwaldoboletus, namely
B. xylophilus (Petch) Both & B. Ortiz [
17].
B. xylophilus is an edible mushroom with a delicious taste and a crispy texture. In the Yunnan region, it can be sold at a price ranging from CNY 60 to 100 per kilogram (approximately to USD 8 - 14). Additionally, the market demand for it is expected to continuously expand.
The fruiting body of
B. xylophilus, is moderate size and can be found either solitary or in clusters, boasts an aesthetically pleasing mushroom form. This species also displays a yellow-brown to brown cap and a stipe that ranges from yellow-brown to reddish-brown. This species also displays a distinctive yellow mycelium at the stipe’ s base. Additionally, its spores are diminutive, typically oval or spherical in shape [
17]. The flesh is yellowish and turns blue rapidly after injury. As time passes, the color of the injured part gradually darkens [
17].
B. xylophilus is an endangered species with few wild resources and low wild yield. Therefore, the biological characteristics and cultivation of B. xylophilus were studied, laying a foundation for the resource protection and development and utilization of B. xylophilus.
2. Materials and Methods
2.1. Isolation
Fruiting bodies of wild
B. xylophilus were collected from the rubber forest of Jinghong City, Xishuangbanna Dai Autonomous Prefecture, Yunnan Province (
Figure 1). The morphological structure was recorded. The soil particles at the root of the fruiting body were removed. The mycelia were isolated from the fruiting bodies and cultured on PD medium (potato 200.0 g, glucose 20.0 g, yeast extract 2.0 g, MgSO
4 1.0 g, KH
2PO
4 1.0 g, agar 18.0 g, water up to 1 L, pH not adjusted). The isolated strains were named YITC-BU001, YITC-BU002 and YITC-BU003 respectively. And YITC-BU001 strain was used for the experiments of biological characteristics. Mycelial cultures were incubated at 28 ℃ for 15 days. The cultures were kept on PD slants at 15 ℃.
2.2. Effect of Carbon and Nitrogen Source
To assess mycelial growth, six different carbon source media were utilized. Potato dextrose PD medium, devoid of glucose, was added with 20 g/L carbon source comprising one of the following: glucose, fructose, sucrose, mannitol, maltose, or soluble starch. The medium was sterilized by autoclaving at 121 ℃ for 30 minutes. 20 mL of the media was dispensed into each 9-cm-diameter Petri dish. A 5-mm-diameter plug of mycelium from the edge of a 15-day-old culture was inoculated on the media. Each Petri dish was sealed with Parafilm to mitigate contamination risks. Incubation of the cultures was carried out in the dark at 28 ℃. The Colony diameters were measured at 5-day intervals, and each treatment was repeated 10 times.
Six distinct nitrogen source media were employed to evaluate mycelial growth. PD medium (without yeast extract) was added with 2 g/L nitrogen source comprising one of the following: tryptone, beef extract, yeast extract, ammonium tartrate, KNO3 and NH4NO3. The subsequent procedures were identical to those of the carbon source experiment.
2.3. Effect of Inorganic Salt
Six inorganic salt media were used to test the growth ability of mycelia. PD medium (without MgSO4, KH2PO4) was added with 1 g/L inorganic salt comprising one of the following: NaCl, MgSO4, KH2PO4, MnSO4, CaSO4, NaNO3. Cultures were incubated in darkness at 28 ℃. The colony diameter was measured every 5 days, and each treatment was repeated 10 times.
2.4. Effect of Temperature and pH
A 5-mm-diameter plug of mycelium was inoculated on PD medium plates from the edge of a 15-day-old culture, then incubated at 15, 20, 23, 25, 28, 30 and 35 ℃ in the darkness. The colony diameter was measured every 5 days, and each treatment was repeated 10 times.
A 5-mm-diameter plug of mycelium was inoculated on PD medium plates from the edge of a 15-day-old culture with different pH. The pH was adjusted to 4.0, 5.0, 6.0, 7.0 and 8.0 with 0.1 mol/L NaOH or 0.1 mol/L HCL. The cultures were incubated in darkness at 28 ℃. The colony diameter was measured every 5 days, and each treatment was repeated 10 times.
2.5. Orthogonal Experiment
According to the screening results of carbon source, nitrogen source, inorganic salt and temperature conditions, the best three levels were selected in each condition, and the orthogonal experiment of four factors and three levels was carried out. In the orthogonal experiment, the mother culture medium was replaced the corresponding carbon source, nitrogen source and inorganic salt, and the experiment was carried out at the corresponding temperature.
2.6. Preparation Of Liquid Culture
200 g potato and 20 g bran were boiled with 1 liter of water for 20 minutes, and the filtrate was collected. 15 g glucose, 2 g yeast extract, 1 g MgSO4, 1 g KH2PO4, and 2 tablets of vitamin B1 (included 10 mg of Vitamin B1) were added to the filtrate and dissolved, pH was not adjusted. The liquid medium was added to 1 L and sub-packed into a 500 mL triangular flask, each containing 250 mL of liquid medium. The media were autoclaved at 121 ℃ for 30 minutes. Four or five 0.5 cm3 plugs of mycelium were inoculated in the liquid media. Cultures were incubated on a shaker (140 rpm/min) in darkness at 28 ℃ for 7 days.
2.7. Solid Substrate Inoculums
The cultivation medium contained 40% rubber sawdust, 35% rubber wood bits, 15% bagasse, 8% corn flour, 1% sucrose and 1% calcium carbonate. The cultivation medium components were mixed in their respective proportions, and water was added to moisten the medium, adjusting its water content to 60~65%. Each polypropylene bag was filled with 1.0-1.1 kg of the cultivation medium. The media were autoclaved at 121 ℃ for 2 hours and cooled to ambient temperature before inoculation. A volume of 10~15 mL of liquid inoculum was inoculated into each cultivation bag (17×35×0.07 cm). The cultures were cultured in darkness at 28 ℃. The mycelium grew from the inoculation surface as the starting point, and the mycelium grew downward to the full bag as the end point. The distance from the inoculation site to the point of full colonization was measured to calculate the mycelial growth rate within the cultivation medium.
2.8. Fructification
The casing materials were composed of peat and vegetable garden soil mixed in a 1:1 volume ratio, casing layer with a thickness of about 3-4 cm. Once the bags were fully colonized by mycelium, their surfaces were cased with the soil mixture. The cased mushroom bags were transferred to the mushroom cultivation house. The temperature in the mushroom cultivation house was maintained at 28-30 ℃, and the relative humidity was 80%~85%.
When the mycelium grows to the surface of the casing layer and the primordia is formed, the cultures were subjected to a temperature of 27-29 ℃ and a light intensity of 1000 lx in a 12 hour light/dark cycle. The quantities of primordia formed within each bag as well as those of the mature fruiting bodies were duly recorded. Subsequently, the yield of fresh mushrooms was accurately measured and the biological conversion rate was calculated.
2.9. Morphological Observation and Molecular Identification
The morphological characteristics of the fruiting bodies of artificially cultivated B. xylophilus were observed and described. The morphology of mycelia and basidiospores were observed under Zeiss microscope (ZEISS AxioScope A1), at a magnification of 40 times (40X).
Genome DNA of fruiting bodies of artificially cultivated B. xylophilus strains YITC-BU001, YITC-BU002 and YITC-BU003 was extracted by plant genome extraction kit (Beijing Tsingke Biotech Co., Ltd.). Using ITS5/ITS4 and LR0R/LR5 as primer pairs, the ITS and 28S rDNA fragments of the strain were amplified by PCR. The parameters of PCR reaction were: pre-denaturation at 98 ℃ for 2 min; 98 ℃ for 10 s, 56 ℃ for 10 s and 72 ℃ for 10 s, totally 35 cycles. After amplification at 72 ℃, it was extended for 5 minutes. After the PCR amplification product was detected by 1.2% agarose gel electrophoresis, the DNA was purified and recovered by purification kit, and the amplification products were sent to Qingke Biotechnology Co., Ltd. for gene sequencing. The sequencing results were spliced by Contig Express software and submitted to GenBank. Based on the outcomes of the BLAST online comparison, the strains featuring high coverage and similarity were chosen, and the phylogenetic tree was constructed through cluster analysis using the software MEGA 6.0.
4. Discussion
The genus
Buchwaldoboletus does not engage in mycorrhizal associations, instead, it is characterized as saprophytic or lignicolous [
12,
13]. In this study, the different carbon sources, nitrogen sources and inorganic salts had effects on the mycelium growth of
B. xylophilus. The best combination was determined by orthogonal experiment as follows: glucose, ammonium nitrate and potassium dihydrogen phosphate. The results are consistent with the optimal carbon sources for mycelial growth of
Phlebopus portentosus and
Boletus edulis, yet different from nitrogen sources and inorganic salts [
29,
30]. Cheng et al [
31] reported that glucose was the best carbon source for most macrofungi.
B. xylophilus preferred ammonium nitrogen, such as ammonium tartrate and ammonium nitrate, while other edible fungi (such as
Clitocybe fragrans,
Polyporus tuberaster,
Flammulina filiformis) preferred organic nitrogen sources such as peptone, beef extract and yeast powder [
32,
33]. This indicates that various mushroom species have distinct nutritional requirements.
In this study, the optimal growth temperature for B. xylophilus was determined to be 28 ℃ and the optimal pH was within the range of 5 to 6. When the temperature is below 15 ℃, the mycelium cannot grow, and when the temperature is above 30 ℃, the mycelium is sparse, white, and grows irregularly. This is similar to the optimal growth temperature and pH value for
P. portentosus and
B. edulis mycelium [
29,
34].
Phlebopus spongiosus has the highest mycelial growth rate and biomass at 30 ℃ and a pH value of 5 [
35], while some edible mushrooms have lower mycelial growth temperatures, such as
Leccinum aurantiacum and
Lepista sordida [
36,
37].
Mycorrhizal edible fungi, such as
B. edulis,
Tricholoma matsuake,
Tuber indicum and
Thelephora ganbajun, are highly valued for their unique flavors and potential health benefits [
38,
39,
40,
41]. These fungi form symbiotic relationships with the roots of specific host plants, a process that is essential for their growth and reproduction [
42]. The complexity of this symbiotic relationship poses distinctive challenges in the field of artificial cultivation. Artificial cultivation represents a crucial approach for the preservation, advancement, and utilization of wild edible fungi. It can not only protect endangered species but also fulfill the sampling needs for scientific research. Some scholars have been trying to research the cultivation of wild bolete mushrooms [
43]. However, the majority of boletes fall into the category of ectomycorrhiza fungi. They form a mycorrhizal structure in association with higher plants like those in the Pinaceae and Fagaceae families. This characteristic makes them difficult to cultivate artificially in mushroom houses [
44,
45,
46,
47].
The genus
Phlebopus is a tropical and subtropical unique edible fungus, which usually grows with
Citrus maxima,
Mangifera indica,
Eriobotrya japonica and other fruit trees in the wild [
48,
49,
50]. Among them,
P. portentosus and
Phlebopus roseus can form a special insect gall structure with plant roots and scale insects [
28,
51,
52,
53].
P. portentosus is the first edible bolete in the world to achieve industrial cultivation and currently. At present, China has realized year-round industrial cultivation and production, with the daily output of fresh mushrooms reaching up to 16 tons [
29,
54]. The method of artificial cultivation of
P. spongiosus was reported, and the yield was increased through high-voltage pulsed stimulation [
35,
55].
P. portentosus is not a typical saprophytic edible fungus, it has certain saprophytic properties, however, its genome lacks or only has a small amount of genes related to lignin and cellulose degradation [
56,
57]. However, the cultivation research of other boletes species is still in the initial stage, such as
B. edulis,
B. tomentipes, and
B. albidus, which are in the screening and optimization stage of mother culture medium and mycelial growth conditions, and the mature fruiting bodies have not yet been cultivated in mushroom houses [
58,
59].
Buchwaldoboletus is different from
Phlebopus, which can be distinguished by habitats [
15], and the molecular data from this study confirm their genetic remoteness from one another. In addition,
P. portentosus and
P. spongiosus will form a large number of sclerotia in the wild and pure culture [
35,
60], while
B. xylophilus has not been observed to form sclerotia, neither in its natural environment nor under artificial cultivation conditions.
Separation from the host plants is a necessary condition for industrial year-round cultivation and production of edible fungi. In this study, the artificial cultivation of
B. xylophilus in mushroom house was successfully achieved. The mycelium
of B. Xylophilus grows strong in a culture medium containing of 40% rubber sawdust, 35% rubber wood bits, 15% bagasse, 8% corn flour, 1% sucrose and 1% calcium carbonate. The mycelium of
P. portentosus and
P. spongiosus grows well in rice and sawdust medium, while the former can also grow rapidly in sorghum and sawdust medium [
29,
35,
61]. Adding 25% to 50% rice husk in eucalyptus sawdust can effectively increase the yield of
Pleurotus ostreatus [
62], suggesting that edible fungi varieties exhibit diverse utilization and requirements for cultivation substrates.
B. xylophilus has strong saprophytic properties. During the mycelial growth process, the cultivation substrates are gradually degraded, and the culture medium become soft. After casing with soil, one mushroom bag can mature 1-11 fruiting bodies, and the average fresh mushroom yield of
B. xylophilus is 131.07±29.38 g/bag, with a biological efficiency of 28.48±6.39%. Inoculating
Buchwaldoboletus hemichrysus or
B. lignicola on wood alone, the mass of wood blocks decreased by 35~65% after 6 months of continuous culture [
63], which indicated that the genus
Buchwaldoboletus had strong ability to degrade lignin and cellulose.
Author Contributions
Conceptualization, T.W.Y., H.J.M. and C.X.Z.; methodology, T.W.Y., X.J.X. and C.X.Z.; software, L.M.D., Y.W.F. and T.W.Y.; validation, J.L., X.J.X. and F.G.; formal analysis, T.W.Y., S.P.J. and L.M.D.; investigation, M.X.H., J.L., F.G. and C.X.Z.; data curation, T.W.Y. and C.X.Z.; writing—original draft preparation, T.W.Y. and L.M.D.; writing—review and editing, H.J.M. and C.X.Z.; visualization, T.W.Y. and C.X.Z.; project administration, H.J.M. and C.X.Z.; funding acquisition, H.J.M., T.W.Y. and C.X.Z. All authors have read and agreed to the published version of the manuscript.